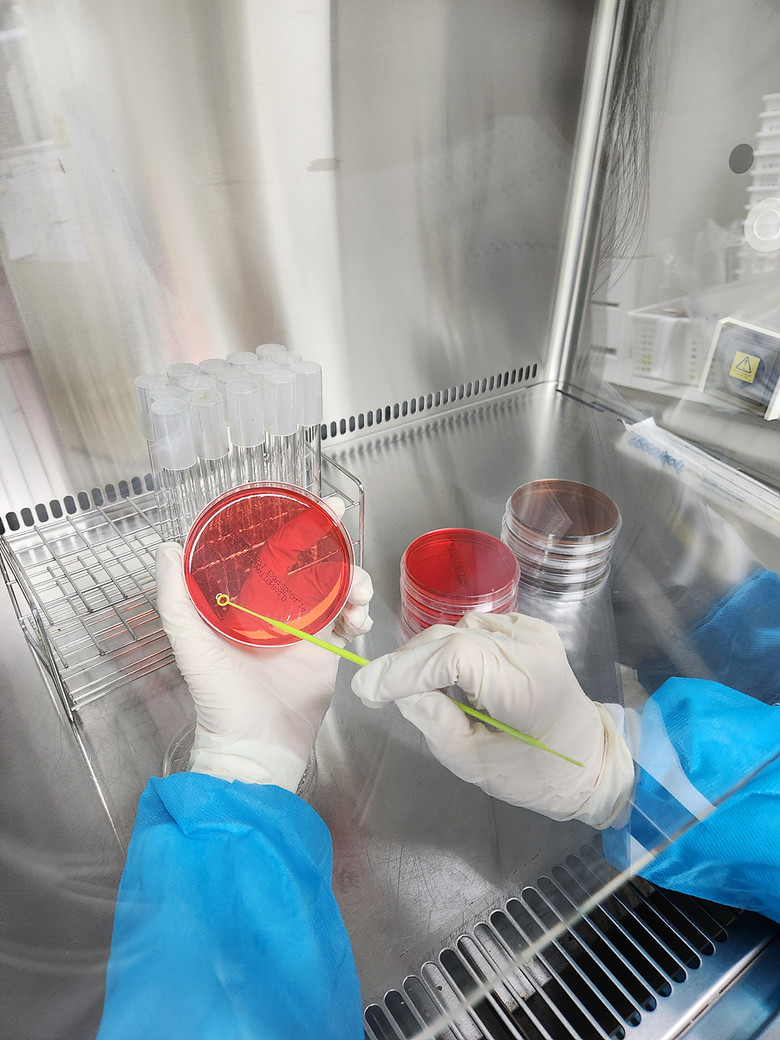

보건환경연구원은 시·구·군 위생부서와 교육청 합동으로 3월 4일(화)부터 28일(금)까지 유치원 및 초·중·고등학교 총 290개 급식소 930건에 대해 위생 검사를 진행할 예정이다.

최근 식중독 발생 중 집단급식소 비율이 높은 만큼 급식소에서 사용하는 칼, 도마, 식판 등 조리기구와 위생 우려 조리식품에 대해 대장균, 살모넬라 등 미생물 항목을 중점 검사한다.
연구원은 지난해 신학기에도 시·교육청과 함께 학교급식 안전성 확인을 위해 관내 유치원 48곳, 초·중·고등학교 229곳, 특수학교 6곳 등 총 283개교의 조리기구 및 조리식품 908건을 검사한 결과 모두 적합했다.
신상희 보건환경연구원장은 “학교급식은 동시에 많은 학생들이 이용하는 만큼 집단식중독 발생 우려가 있으므로 앞으로도 시·교육청과 함께 선제적 예방을 위해 노력하겠다”고 말했다.
[저작권자ⓒ 세계타임즈. 무단전재-재배포 금지]












































